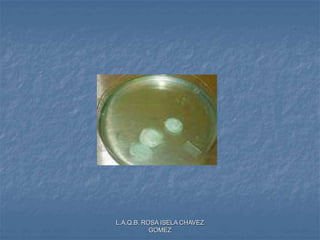
L.A.Q.B. ROSA ISELA CHAVEZ
GOMEZ

Las tres oraciones son:
1. Los cestodos son parásitos intestinales comunes en humanos y animales que pueden causar taeniasis o cisticercosis dependiendo de su estado de vida.
2. Las especies más importantes son Taenia solium, T. saginata, e Hymenolepis nana, cuyos estados adultos se alojan en el intestino delgado humano.
3. Otro cestodo importante es Echinococcus, cuyo metacéstodo puede causar hidatidosis al alojarse en órganos como el hígado